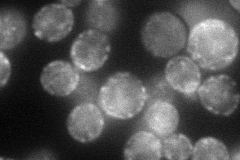
YKR058W
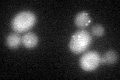
YKR058W
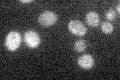
YKR058W

View description
Self-glucosylating initiator of glycogen synthesis, also glucosylates n-dodecyl-beta-D-maltoside; similar to mammalian glycogenin
Localization:
Intensity:
Fold change:
Significance:
-
C’ GFP library in SD

below threshold19.69 -
N' NOP1pr-GFP in SD
cell periphery,punctate77.3593 -
N' TEF2pr-mCherry in SD

cell periphery,vacuole21.6849 -
N' NATIVEpr-GFP in SD

below threshold18.4539 -
N' TEF2pr-VC and Cyto-VN in SD

#N/A0 -
C’ GFP library in SD+DTT
cytosol23.771.2No -
C’ GFP library in SD+H2O2

cytosol19.941.01No -
C’ GFP library in Starvation Media
cytosol23.581.19No -
C’ GFP library on the background of Pup2-DaMP

below threshold -
C’ GFP library on the background of CCT mutant

below threshold22.37911.13633No
